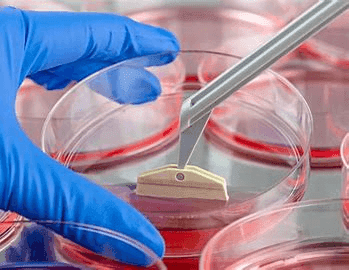

Cell Harvesting System Market Industry Analysis Report 2022-2028

This report on Cell Harvesting System Market mentions the latest trends, growth prospects and global forecast for the upcoming years. The report also covers the market size, share, industry opportunities and consumption data. The financial analysis, new products launch and other latest development of the top Cell Harvesting System market players help in assessing the competitive scenario of the industry.
The entire cell harvesting system market has been sub-categorized into application and end-use. The report provides an analysis of these subsets with respect to the geographical segmentation. This research study will keep marketer informed and helps to identify the target demographics for a product or service.
Request a FREE Sample Copy of Global Cell Harvesting System Market Report with Full TOC At: https://www.valuemarketresearch.com/contact/cell-harvesting-system-market/download-sample
By Application
Umbilical Cord
Bone Marrow
Peripheral Blood
Adipose Tissue
Other Sources
By End-Use
Hospital
Clinic
Academic institutes
R&D Centers
The research report also covers the comprehensive profiles of the key players in the market and an in-depth view of the competitive landscape worldwide. The major players in the cell harvesting system market include Argos Technologies Incorporation, Perkin Elmer, Inc., BRAND GmBh+ CO KG, Arthrex Inc., Avita Medical, Tomtec, Bertin Technologies, Terumo Corporation, Teleflex, Inc. This section includes a holistic view of the competitive landscape that includes various strategic developments such as key mergers & acquisitions, future capacities, partnerships, financial overviews, collaborations, new product developments, new product launches, and other developments.
This section covers regional segmentation which accentuates on current and future demand for cell harvesting system market across North America, Europe, Asia-Pacific, Latin America, and Middle East & Africa. Further, the report focuses on demand for individual application segment across all the prominent regions.
Browse Full Global Cell Harvesting System Market Research Report With TOC At: https://www.valuemarketresearch.com/report/cell-harvesting-system-market
About Us:
Value Market Research was established with the vision to ease decision making and empower the strategists by providing them with holistic market information.
We facilitate clients with syndicate research reports and customized research reports on 25+ industries with global as well as regional coverage.
Contact:
Value Market Research
401/402, TFM, Nagras Road, Aundh, Pune-7.
Maharashtra, INDIA.
Tel: +1-888-294-1147
Email: sales@valuemarketresearch.com
Website: https://www.valuemarketresearch.com
Appreciate the creator